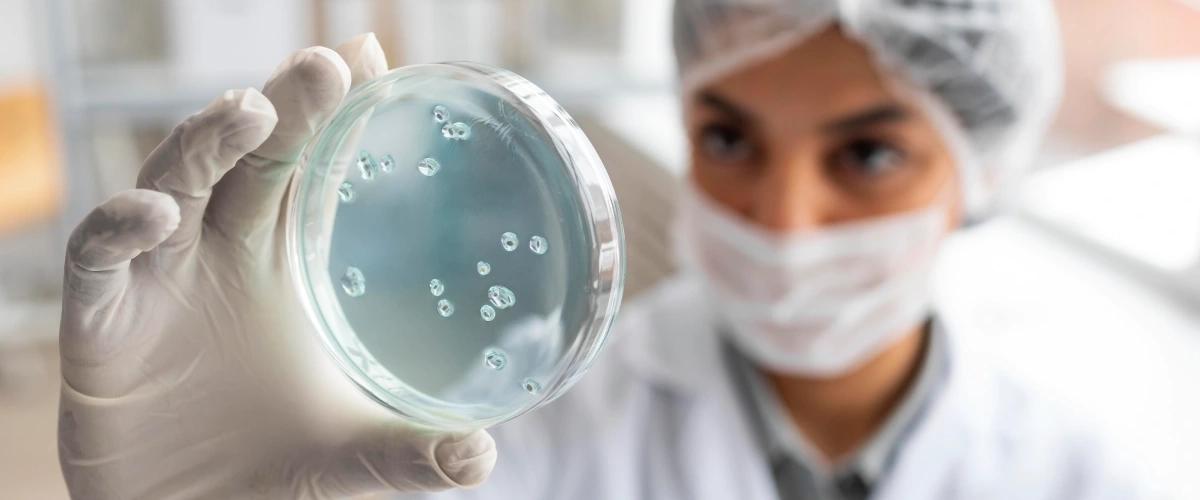
TODO:

Влияние микробиоты на здоровье активно изучается многими ученые. В новой работе команда из Стэнфорда наблюдала за добровольцами в возрасте от 29 до 75 лет в течение шести лет, чтобы определить признаки здоровой микробиоты кишечника, рта, носа и кожи, а также оценить влияние изменений в составе бактерий на состояние здоровья людей.
«Изучение бактерий на различных участках тела в течение длительного периода позволило нам впервые взглянуть на микробиоту, как на единую систему», — заявил соавтор работы Майкл Снайдер. По его словам, диета, генетика и иммунитет формируют эту экосистему.
В рамках эксперимента участники регулярно сдавали образцы микробиоты, а во время болезней или приема антибиотиков проводились дополнительные тесты.
Сначала ученые заметили, что во время острой болезни, например, при простуде состав микробиоты изменяется. При развитии хронического заболевания происходят аналогичные изменения, однако они носят уже длительный характер. Примечательно, что изменения в одном участке тела приводят к каскадной реакции, быстро изменения состав бактерий в других.
Особенно удивительным оказалось открытие о стабильности микроботы.
Установлено, что индивидуальные наборы бактерий у конкретного человека были более стабильными, чем другие распространенные бактерии. Эти выводы также доказывают, что персональная микробиота конкретного человека стабильна и отличается от микробиоты других людей, что отчасти объясняет разные показатели здоровья.
«Вместе результаты указывают на важность персональной микробиоты для метаболического и иммунного здоровья человека», — заявил Снайдер. Ученые понимают, что диета и образ жизни играют ключевое значение в составе бактерий, поэтому в дальнейших исследованиях они изучат наиболее благоприятные и негативные факторы для поддержки баланса бактерий.
Ранее в другом исследовании ученые обнаружили, что резистентные бактерии могут сохраняться в организме человека годами. Они не только повышают риски инфекций, но и служат резервуаром для инфицирования других людей.